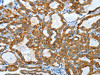
The image on the left is immunohistochemistry of paraffin-embedded Human thyroid cancer tissue using CSB-PA268168 (KRT40 Antibody) at dilution 1/50, on the right is treated with fusion protein. (Original magnification: ×200)

Cusabio Polyclonal Antibodies
KRT40 Antibody | CSB-PA268168
- SKU:
- CSB-PA268168
- Availability:
- 3 to 7 Working Days
Description
KRT40 Antibody | CSB-PA268168 | Cusabio
KRT40 Antibody is Available at Gentaur Genprice with the fastest delivery.
Online Order Payment is possible or send quotation to info@gentaur.com.
Product Type: Polyclonal Antibody
Target Names: KRT40
Aliases: keratin 40
Background: This gene encodes a member of the type I (acidic) keratin family, which belongs to the superfamily of intermediate filament (IF) proteins. Keratins are heteropolymeric structural proteins which form the intermediate filament. These filaments, along with actin microfilaments and microtubules, compose the cytoskeleton of epithelial cells. The type I keratin genes are clustered in a region of chromosome 17q12-q21.
Isotype: IgG
Conjugate: Non-conjugated
Clonality: Polyclonal
Uniport ID: Q6A162
Host Species: Rabbit
Species Reactivity: Human, Mouse, Rat
Immunogen: Fusion protein of human KRT40
Immunogen Species: Human
Applications: ELISA, WB, IHC
Tested Applications: ELISA, WB, IHC;ELISA:1:2000-1:5000, WB:1:500-1:2000, IHC:1:50-1:200
Purification Method: Antigen affinity purification
Dilution Ratio1: ELISA:1:2000-1:5000
Dilution Ratio2: WB:1:500-1:2000
Dilution Ratio3: IHC:1:50-1:200
Dilution Ratio4:
Dilution Ratio5:
Dilution Ratio6:
Buffer: -20°C, pH7.4 PBS, 0.05% NaN3, 40% Glycerol
Form: Liquid
Storage: Upon receipt, store at -20°C or -80°C. Avoid repeated freeze.
Initial Research Areas: Signal Transduction
Research Areas: Signal transduction